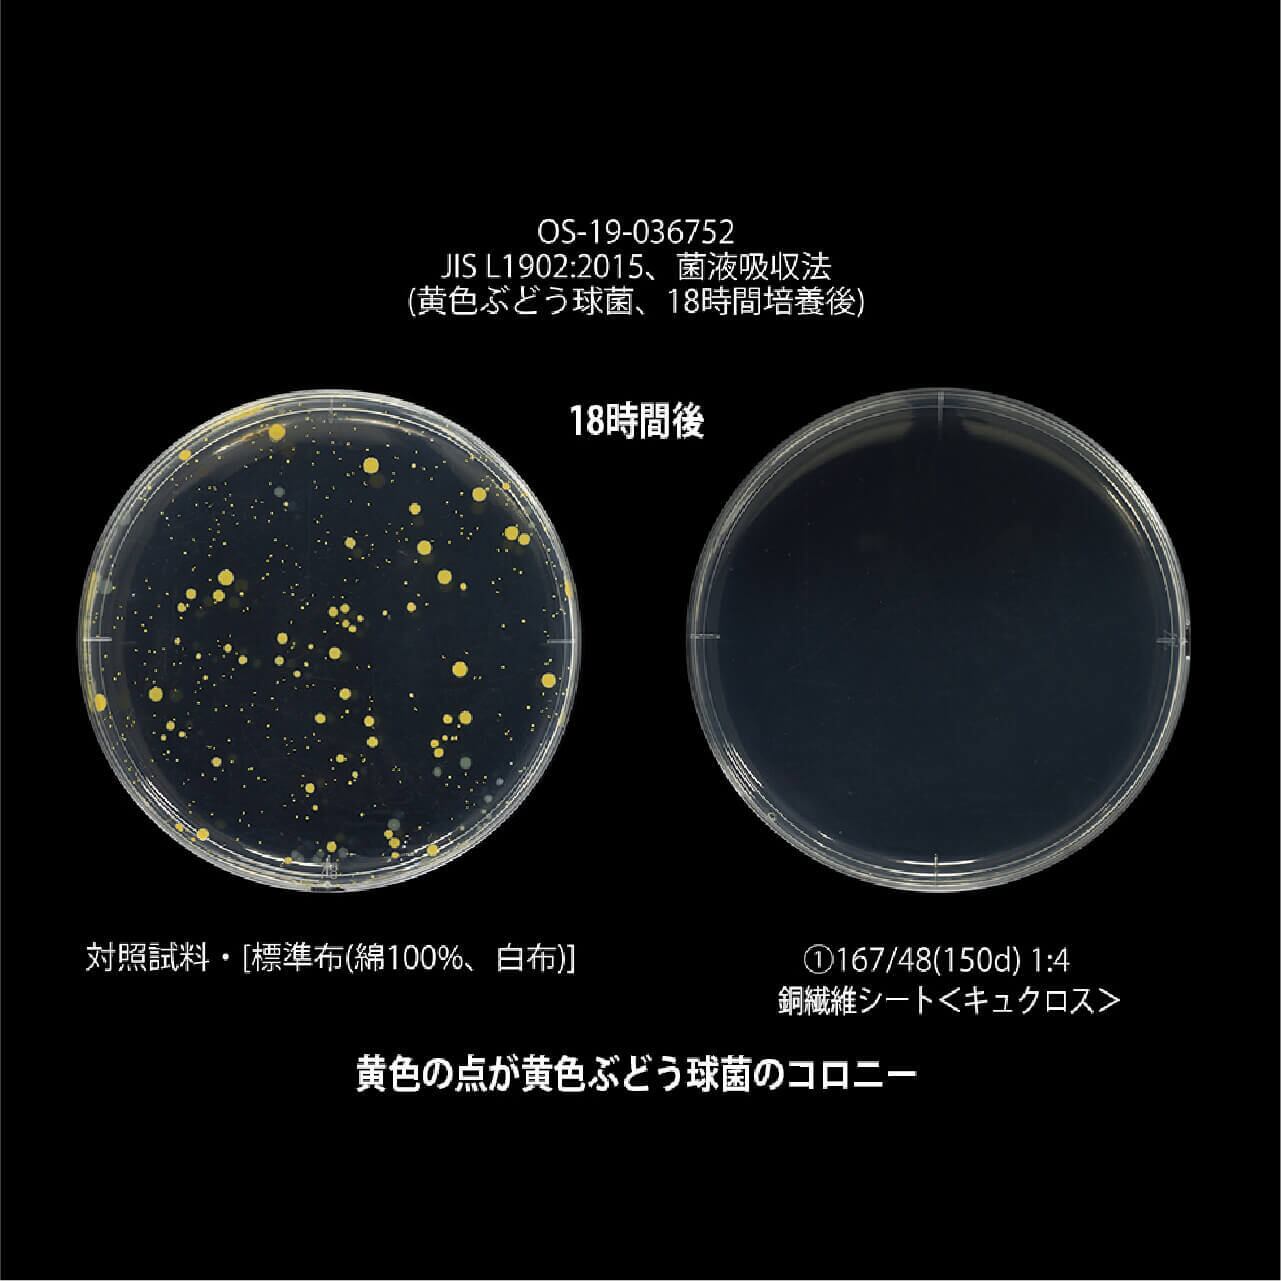

Cu-Cloth ハンカチ 正方形24×24㎝ 【よろけ縞】
¥1,500
International shipping available
銅繊維シート入りの抗菌ハンカチ
私たちが暮らしの中で何気なく触れる「布」。
その布が、もっと清潔で、もっと安心できるものであってほしい。
そんな想いから〈キュクロス〉の開発は始まりました。
きっかけは、介護現場で聞いた声でした。
「排泄物や汗、体臭など、混ざり合う臭いに悩んでいる」
――悪臭の原因は、菌の増殖。ならばその根本を断てないか。
そこで私たちは、昔から高い抗菌力で知られる銅に着目。
2018年より研究を重ね、銅の抗菌性を繊維として活かすことに成功しました。
わずか3時間で99%以上の菌を抑える、その確かな力。
それを、日常に取り入れやすい「ハンカチ」というかたちにしました。
素材は、染色の町・新潟県阿賀野市の手ぬぐい生地。
270年以上続く老舗〈越後亀紺屋〉の注ぎ染めによる美しい色合いと、
吸水性の高い綿素材のやさしさを生かし、
中央に抗菌銅繊維シート〈キュクロス〉を挟んだ三層構造に仕立てています。
「拭く」「触れる」「包む」――日々の小さな所作を、より衛生的でここちよく。
暮らしの清潔を、銅のチカラでさりげなく支える。
〈キュクロス〉は、そんな新しい“布のあり方”を提案します。
商品詳細
■ 商品名 : Cu-Cloth ハンカチ 正方形24×24㎝ 【よろけ縞】
■ 商品コード : 5208785
■ 外形寸法 : 24x24cm
■ 材質 :
表地・裏地:綿100%
芯地:銅繊維素材(ポリエステル100%、極細銅線)
■ 生産国 : 日本
取扱い上の注意
● 表生地は色落ちしやすいので他のものと区別して洗濯してください。
● 漂白剤、柔軟剤は使用しないでください。
● 洗濯は液温40°Cを限界に洗濯してください。
● アイロンがけはあて布をし底面110°Cを限界としスチームなしで仕上げてください。
● 乾燥は日陰の平干しをしてください。
● ブラシでこすらないでください。
緑青発生の注意
本製品は銅を素材に使用しているため、ご使用いただく中で緑青(銅が酸化することによって発生する緑色の錆)が発生することがあります。
● 濡れたまま放置しておくと銅イオンの発生で緑青が出ることがあります。定期的に洗濯し完全に乾燥させてご使用ください。
● 緑青が発生しましたらクエン酸に数分浸し良く水洗いして完全に乾かしてお使いください。また酢と塩を1:1で混ぜ合わせた液体に、15分ほど漬け込むと綺麗になります。その後中性洗剤で洗い乾かすと、酢の臭いも落ちます。
● 緑青発生から長く放置しておくと除去できなくなります。
※緑青は人体に健康被害はありません。
-
レビュー
(1)